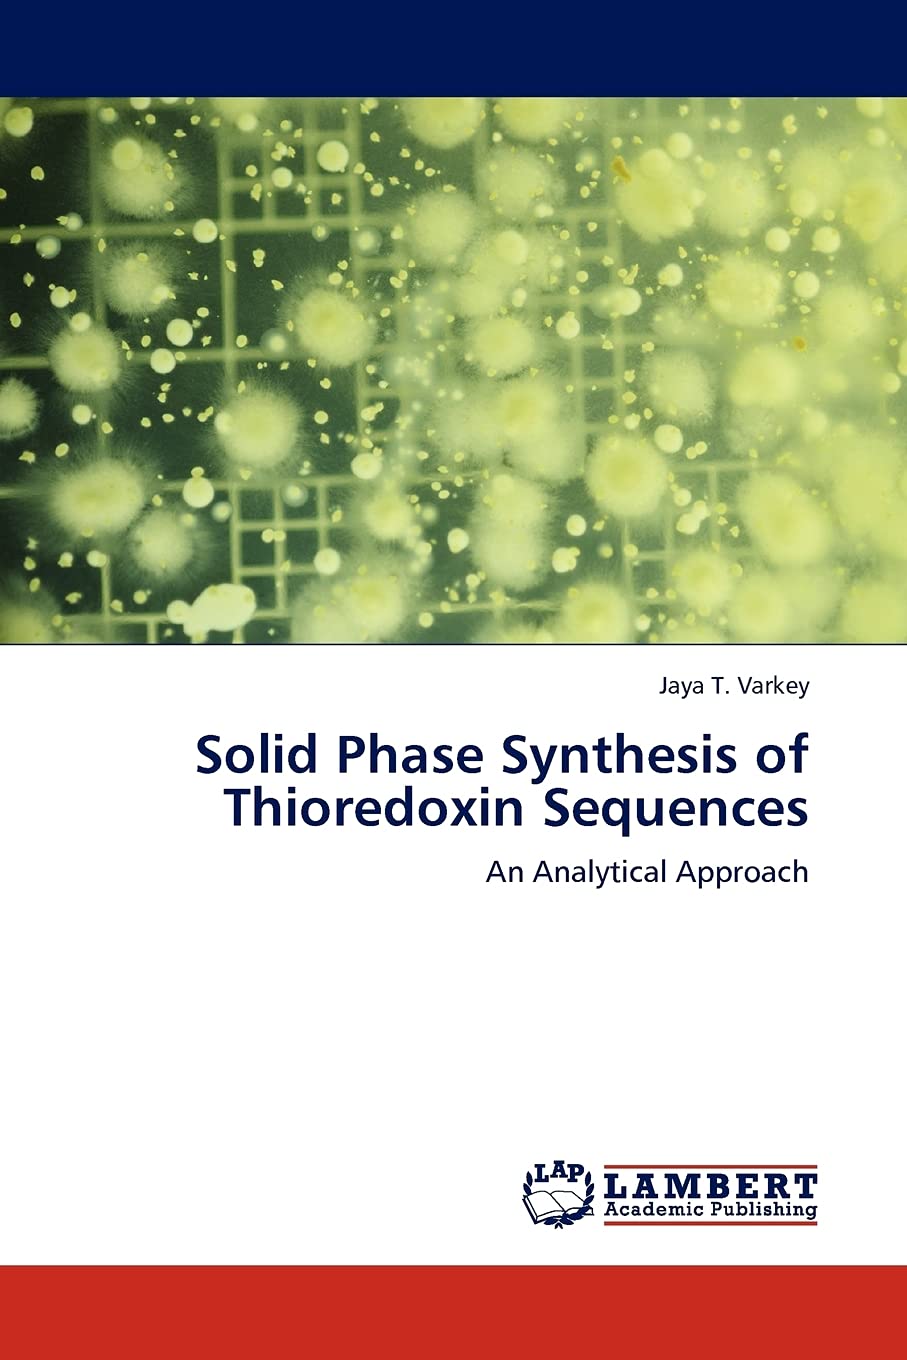

Title
Solid Phase Synthesis of Thioredoxin Sequences: An Analytical Approach,Used
Sold by Ergodebooks, an authorized reseller.
Returns accepted within 30 days | support@ergodebooks.com
Shipping Information
- Free Standard Shipping — United States only
- Processing Time: 1–3 business days
- Estimated Delivery: 3–5 business days after dispatch
- Double-boxed, fully insured & discreetly packaged
- Tracking number sent via email once dispatched
- Orders over $250 require signature upon delivery. Taxes calculated at checkout.
Returns & Refund
Returns accepted within 30 days of delivery.
Damaged or Defective Item
Free return shipping + replacement or full refund
Wrong Item Received
Free return shipping + replacement or full refund
Change of Mind
Return shipping at customer's expense · 25% restocking fee applies
It has been nearly fifty years since the advent of solid phase method for the assembly of peptides. One of the main difficulties facing researchers in this field is that of obtaining quantities of peptides and proteins in a pure state. Isolation of proteins form natural resources can be laborious and often provides only tiny quantities. Investigations dealing with the quantitative aspects of polymersupported reactions have shown that the insoluble support does have a significant dynamic influence on the bound substrates. An efficient polymeric support for peptdide synthesis should have optimum hydrophobichydrophilic balance compatible with the peptide being synthesized. This book illustrates the synthesis and characterization of a novel polymer support, polystyrene crosslinked with 1,6hexanediol diacrylate for the successful synthesis of peptides. The compatibility of the new support is proved by synthesizing sequences of Thioredoxin, which is otherwise difficult to synthesize. Thioredoxin is a naturally occurring sulphur reducing protein containing 108 amino acids. The book is useful to researchers, scientists and academia in studying the intricacies of solid phase synthesis.
⚠️ WARNING (California Proposition 65):
This product may contain chemicals known to the State of California to cause cancer, birth defects, or other reproductive harm.
For more information, please visit www.P65Warnings.ca.gov.

